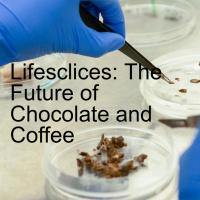

Sinopsis
From a fleet of flourishing businesses to the marvels of mom life, Kay and Shi are teaming up to share their insights for success! With purpose-driven teachings, hilarious conversation, and engaging personal stories designed to live your life with intention, these renowned coaches are here to help you get the most out of your growth. Snag a slice of life and listen now!
Episodios
-
Lifeslices: Being Alike
27/01/2025 Duración: 37minIn the United States, and around the world, people seem to be as far apart, politically, as the North Pole is from the South. But, in matters that are important to all of us, just how far apart are we? Professor Lawrence Torcello of the Rochester Institute of Technology joins host Steve Fisher to discuss why we're so polarized when we're so alike.
-
Lifeslices: Geeking Out at CES
20/01/2025 Duración: 40minCES. The Consumer Electronics Show. Every January in Las Vegas, hundreds of companies show up to exhibit gadgets, software and services to more than 140,000 attendees. One of those is Marc Saltzman, tech reporter for many popular publications and media outlets. Marc brings host Steve Fisher up to date on what's up to date in tech.
-
Lifeslices: Life Underwater
13/01/2025 Duración: 36minOceans cover almost 70% of Earth’s surface. They hold more life than anywhere else. Yet, man has barely scratched the surface. Diver Phil Short and a company called Deep are creating a deep-sea habitat where scientists can live where they work. Phil joins host Steve Fisher to talk about Life Underwater.
-
Lifeslices: Driving Rats
06/01/2025 Duración: 36minCan you teach a rat to drive? Then again, why would you want to? Well, if you’re a neuroscientist like the University of Richmond’s Dr. Kelly Lambert, the challenge was too great and the real-life implications too rich. She joins host Steve Fisher to talk about the study and how it translates to humans.
-
Lifeslices: Christmas message 2024
22/12/2024 Duración: 48sFrom all of us at Lifeslices to all of you. Video available on You Tube, Tik Tok, Facebook and more.
-
Lifeslices: Explaining the Universe
16/12/2024 Duración: 32minHow much do you know about the universe? If you’re like me, not much. There are stars and galaxies and planets and asteroids and meteors. But there’s a lot more you don’t see. Dr. Mustapha Ishak Boushaki is a theoretical physicist, cosmologist and professor at the University of Texas at Dallas. In this episode he's Explaining the Universe to host Steve Fisher.
-
Lifeslices: Ballooning Maven
09/12/2024 Duración: 37minIn the late 60’s hit, Up, Up and Away, The Fifth Dimension sang, “Would you like to ride in my beautiful balloon?” Captain Crystal Stout has been singing it ever since. She’s a true Ballooning Maven. Captain Crystal has logged more air miles than she can count and she’s spreading the gospel of Ballooning to people who may not have otherwise had the opportunity with her Dreamcatcher balloon. She joins host Steve Fisher to talk about her years flying and now bringing it to special needs people.
-
Lifeslices: Everglades Avenger
01/12/2024 Duración: 27minWhen Burmese Pythons were introduced into Florida as part of the exotic pet trade, most owners didn’t realize what they were in for. Burmese pythons can grow to around 20 feet long. Some owners reconsidered their choice of pet and released them into the wild, mostly in the Everglades. Now, with tens of thousands of Burmese Pythons on the loose, the Everglades ecosystem has taken a major hit and a new profession has arisen. Donna Kalil is a Python Elimination Specialist and talks to hos Steve Fisher about the daunting task.
-
Lifeslices: Studying Twins
25/11/2024 Duración: 28minTwins. How they occur is a mystery, but how they behave once they get here, not so much. Thanks to the work of people like Dr. Nancy Segal. She’s been Studying Twins for decades and joins host Steve Fisher to share some of her insights.
-
Lifeslices: Herbalism 101
18/11/2024 Duración: 36minMost people might simply go to the local drug store, herbalists will head into the vast outdoors to fix what ails them. Jim McDonald and Nathan Wright are topnotch Herbalists and teachers. They join host Steve Fisher for an Herbalism 101.
-
The Future of Chocolate and Coffee
11/11/2024 Duración: 29minDo you like chocolate? How about coffee? To many, they are two of nature’s treasures. But between climate change, deforestation and human demand, these precious resources are endangered. A startup company called California Cultured is working to sustainably improve on Mother Nature. Alan Perlstein is the company’s CEO. He joins host Steve Fisher to talk about The Future of Chocolate and Coffee.
-
Designing Humanity
04/11/2024 Duración: 30minSome people fear that computers and virtual reality are robbing us of our humanity, and our interconnectivity with other humans who share our world. What if someone were to argue that we’re not being robbed, we’re being given new avenues, new technology to communicate with those others? Sara Guisto is doing that through her creations, virtual humans. She joins host Steve Fisher to talk about Designing Humanity.
-
The Earthships Are Coming?
28/10/2024 Duración: 32minWhat if someone could build a house that is not only sustainable itself, but can meet all its inhabitants' needs sustainably? Sounds like science fiction? How about science fact? Michael Reynolds is a biotect in Taos, New Mexico, who says he’s got the answer. Earthships. He talks to host Steve Fisher about what they are, what they do and how he's trying to make them affordable for all.
-
Lifeslices: Uplift Malawi
21/10/2024 Duración: 41minYou may have seen a TV show called Survivor. Contestants are taken to some exotic locale and asked to do a task or stunt. At the end of the day, the players may make it to the next round of competition or be eliminated. Heidi Hamels was on that show. She’s here as the founder of a non-profit organization called Uplift Malawi, along with it’s executive director, Alaina Baker, trying to help the children of that country survive. They join host Steve Fisher to talk about the issues plaguing Malawi and how you can help.
-
Lifeslices: Music Man
14/10/2024 Duración: 29minWhen you go to a musical show or concert you tend to look at the person standing in front of the orchestra, waving their arms, and think, I can do that. Chances are, you can’t. It takes a very particular set of skills. Larry Blank is a composer, orchestrator and conductor, based in Los Angeles, New York and London, who has worked with some of the most respected names in theatre, film, television and music. He has those skills and then some. He’s a true Music Man and joins host Steve Fisher to talk about his work on Broadway, film, TV and concert stages around the world.
-
Lifeslices: Saving Orangutans
07/10/2024 Duración: 32minWhat would you do if a member of your family was in danger? I hope you’d say you would do everything you could to save them. I’m not talking about your human family. Did you know that orangutans are among our closest relatives, sharing 97% of our DNA. They’re intelligent, inquisitive, very observant and very much in danger of going extinct in the wild. Leif Cocks, founder of The Orangutan Project, is devoted to keep that from happening. He joins host Steve Fisher to talk about Saving Orangutans. This is Lifeslices!
-
Lifeslices: On Life
23/09/2024 Duración: 28minIf you’ve dwelt on this planet long enough, you’ve likely picked up a lot of wisdom and knowledge. That would make you what’s called a senior citizen. If you choose to put that experience and your surrounding musings on paper, you’re a philosopher. David M. Perkins might not cop to the latter but he definitely acknowledges the former. He’s certainly someone worth listening to as he talks to host Steve Fisher On Life.
-
Lifeslices: Summons to Berlin
16/09/2024 Duración: 35minNazi. Originally the name for a political movement, today, it’s a synonym for evil. Over the course of their Reign of Terror, they destroyed populations and countries, including their own. Joanne Intrator grew up the daughter of German refugees. Her parents were among the lucky ones to escape but it wasn’t unscathed. On his deathbed, her father challenged her to a mission in his old homeland. It would change her life in many ways. Joanne joins host Steve Fisher to talk about her Summons to Berlin.
-
Lifeslices: Out of Focus
09/09/2024 Duración: 38minADHD. Four little letters that can spell big problems for children around the world. While some of those children may outgrow the disorder, millions more won’t and, in fact, may never have been diagnosed to begin with, creating many issues for those adults who are missing the chance for treatment. Dr. J. Russell Ramsey is one of the most preeminent psychologists in the research and treatment of adult ADHD and talks to host Steve Fisher about what it is, how it's diagnosed and how it's treated.
-
Lifeslices: Coexisting with Beavers
02/09/2024 Duración: 33minWhen Mother Nature created beavers, she proved to have a sense of humor. These funny-looking oversized members of the rodent family have buck teeth and large paddle-like tails, perfect for cartoon characters. But she also had a plan, imbuing them with an ecological purpose. Unfortunately, man came along and didn’t see it that way. Farmers and ranchers, not to mention fur traders, drove the beavers away and close to the point of extinction. Now, thanks to organizations like Defenders of Wildlife, beavers are making a comeback. Peggy Darr is one of their Defenders and talks to host Steve Fisher about the pros and cons of adding more beavers to our environment.